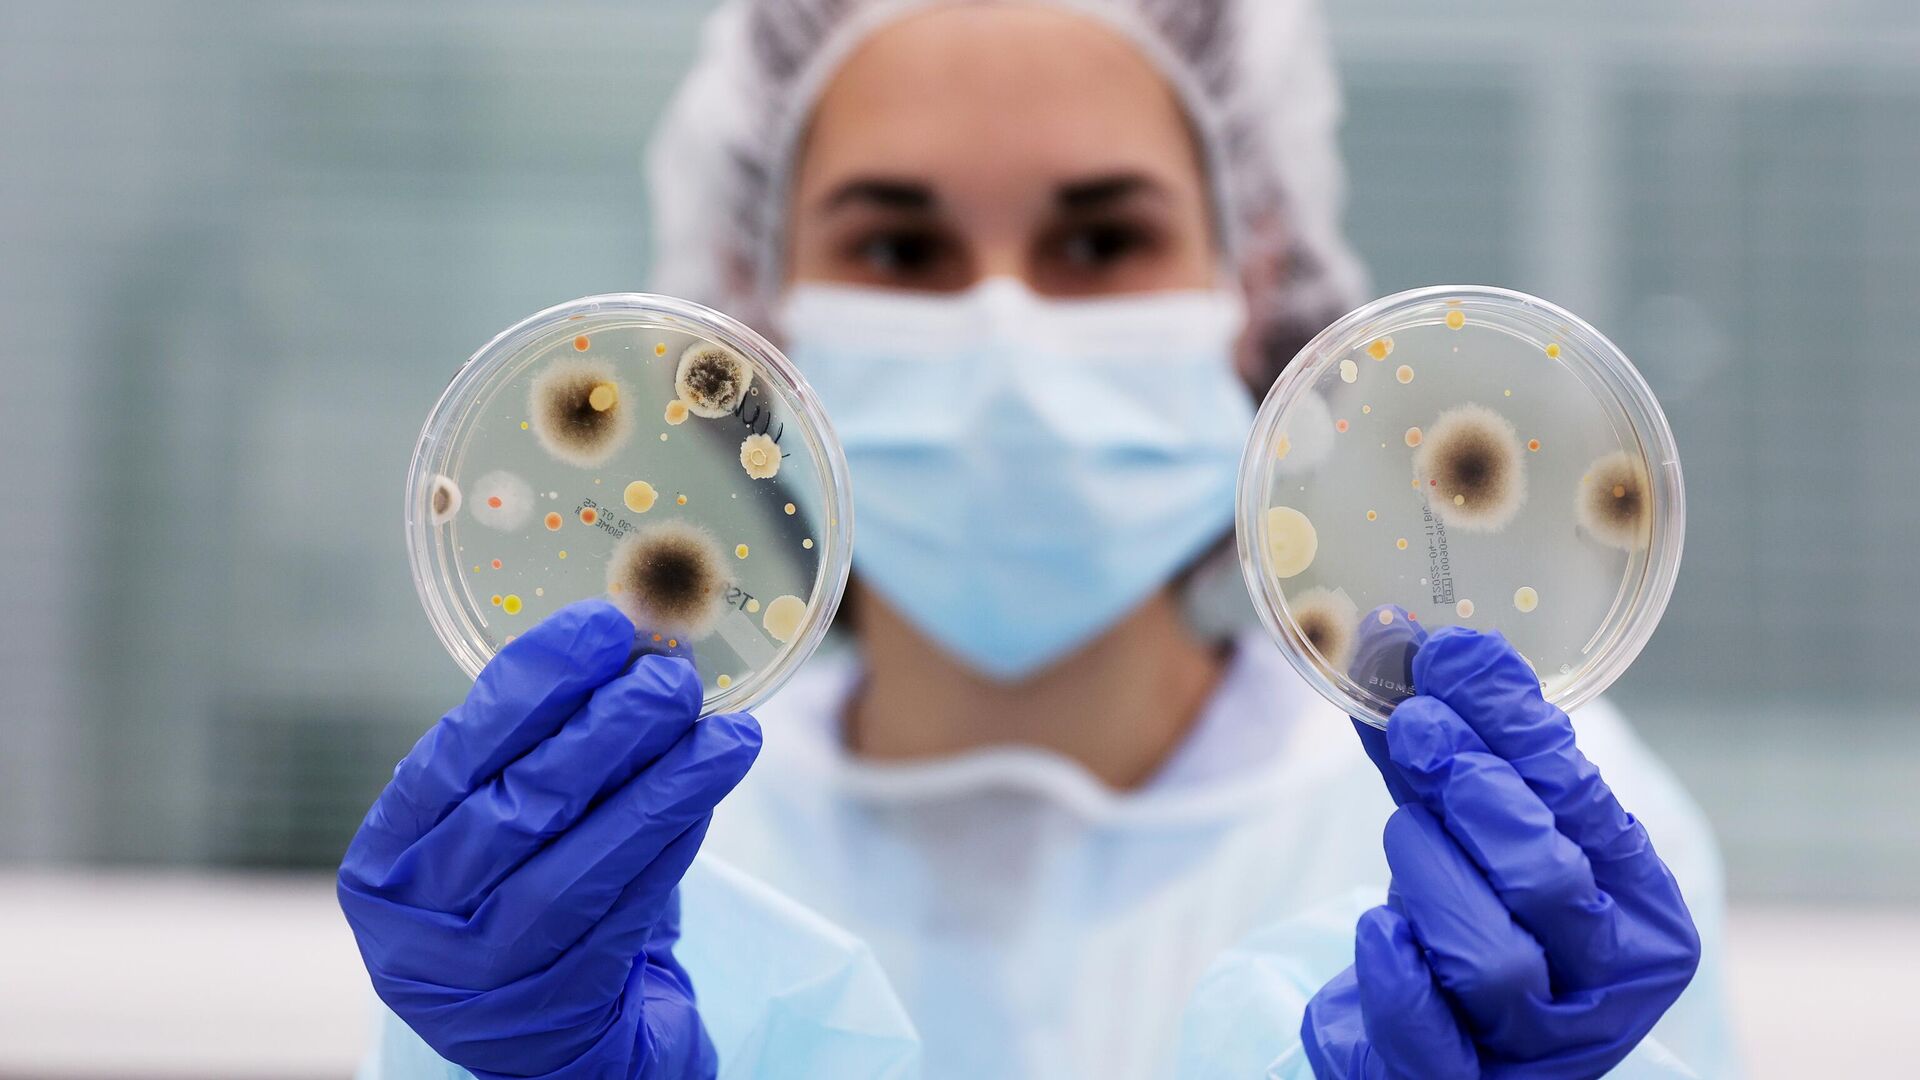

https://sputnik.by/20260414/virusy-kotorye-vyzyvayut-rak--versiya-onkologa-1106196735.html
Вирусы, которые вызывают рак, – версия онколога
Вирусы, которые вызывают рак, – версия онколога
Sputnik Беларусь
Вакцинация от ряда онкогенных вирусов входит в Национальный календарь профилактических прививок и эффективно защищает от инфекции и ее тяжелых осложнений. 14.04.2026, Sputnik Беларусь
2026-04-14T19:19+0300
2026-04-14T19:19+0300
2026-04-15T11:02+0300
общество
здоровье
онкология
вирус
рак
новости беларуси
https://cdnn11.img.sputnik.by/img/07ea/04/0e/1106196546_0:160:3072:1888_1920x0_80_0_0_45a2a8bb6c5c1855b329e79eb9570f52.jpg
Одной из причин развития рака могут быть вирусы, сообщил РИА Новости кандидат медицинских наук, онколог-маммолог Дмитрий Мироненко.Он отметил, что существует несколько теорий развития онкозаболеваний, одна из них предполагает вирусно-генетический механизм.Он уточнил, что онкогенными в настоящее время считается несколько вирусов. По мнению медицинской науки, они способны вызывать мутации в клетках, что впоследствии приводит к развитию злокачественных опухолей.Наибольшей онкогенностью, по словам Мироненко, обладают вирус папилломы человека, вирусы гепатита В и С, вирусы герпеса четвертого и восьмого типов, Т-лимфотропный вирус человека и полиомавирус клеток Меркеля.Защита от вирусовВирус папилломы человека (ВПЧ) рассматривается в настоящее время как основная причина развития рака шейки матки. Эффективной профилактикой заболевания является вакцинация.В Беларуси вакцинация от ВПЧ двух наиболее канцерогенных типов 16 и 18 включена в Национальный календарь профилактических прививок. Осенью 2025 года в республике началась бесплатная вакцинация девочек в возрасте 11 лет.Вирусы гепатита В и С могут привести к развитию онкологических заболеваний вследствие осложнений инфекции. Гепатит В неизлечим (вирус навсегда остается в организме), однако заболеваемость им в Беларуси минимальна: прививка, которую ставят практически 98% новорожденных в первые сутки жизни, эффективно защищает от самого вируса и его осложнений.Вакцинация от гепатита С не входит в перечень обязательных. Однако, своевременное лечение в случае заражения позволяет предотвратить тяжелые последствия, среди которых цирроз и рак печени.Самые интересные и важные новости ищите в нашем Telegram-канале, MAX и Viber. Также следите за нами в Дзен!
новости беларуси
Sputnik Беларусь
media@sputniknews.com
+74956456601
MIA „Rossiya Segodnya“
2026
Sputnik Беларусь
media@sputniknews.com
+74956456601
MIA „Rossiya Segodnya“
Новости
ru_BY
Sputnik Беларусь
media@sputniknews.com
+74956456601
MIA „Rossiya Segodnya“
Sputnik Беларусь
media@sputniknews.com
+74956456601
MIA „Rossiya Segodnya“
общество, здоровье , онкология, вирус, рак, новости беларуси
общество, здоровье , онкология, вирус, рак, новости беларуси
Вирусы, которые вызывают рак, – версия онколога
Вакцинация от ряда онкогенных вирусов входит в Национальный календарь профилактических прививок и эффективно защищает от инфекции и ее тяжелых осложнений.
Одной из причин развития рака могут быть вирусы, сообщил
РИА Новости кандидат медицинских наук, онколог-маммолог Дмитрий Мироненко.
Он отметил, что существует несколько теорий развития онкозаболеваний, одна из них предполагает вирусно-генетический механизм.
"Теория основана на встраивании ДНК или РНК вирусов в геном клетки человека как факторе, инициирующем развитие рака", – пояснил врач.
Он уточнил, что онкогенными в настоящее время считается несколько вирусов. По мнению медицинской науки, они способны вызывать мутации в клетках, что впоследствии приводит к развитию злокачественных опухолей.
Наибольшей онкогенностью, по словам Мироненко, обладают вирус папилломы человека, вирусы гепатита В и С, вирусы герпеса четвертого и восьмого типов, Т-лимфотропный вирус человека и полиомавирус клеток Меркеля.
Вирус папилломы человека (ВПЧ) рассматривается в настоящее время как основная причина развития рака шейки матки. Эффективной профилактикой заболевания является вакцинация.
В Беларуси вакцинация от ВПЧ двух наиболее канцерогенных типов 16 и 18 включена в Национальный календарь профилактических прививок. Осенью 2025 года в республике
началась бесплатная вакцинация девочек в возрасте 11 лет.
Вирусы гепатита В и С могут привести к развитию онкологических заболеваний вследствие осложнений инфекции. Гепатит В неизлечим (вирус навсегда остается в организме), однако заболеваемость им в Беларуси минимальна: прививка, которую ставят практически 98% новорожденных в первые сутки жизни, эффективно защищает от самого вируса и его осложнений.
Вакцинация от гепатита С не входит в перечень обязательных. Однако, своевременное лечение в случае заражения позволяет предотвратить тяжелые последствия, среди которых цирроз и рак печени.
Самые интересные и важные новости ищите в нашем Telegram-канале, MAX и Viber. Также следите за нами в Дзен!